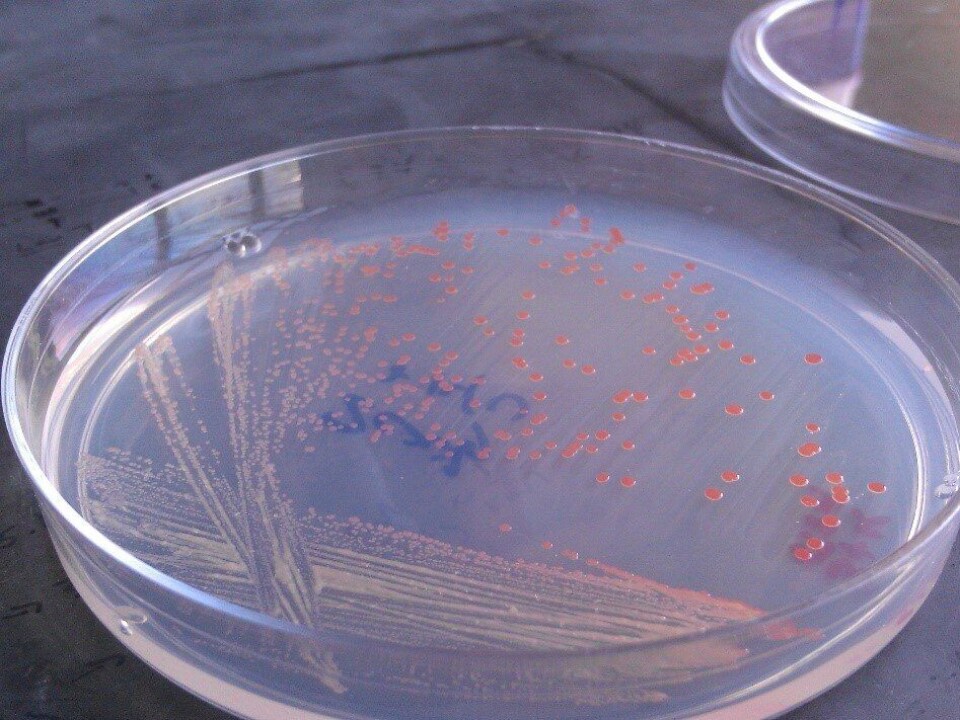

Ny proteinkilde skal gi mindre muddersmak på RAS-fisk
Selskapet KnipBio melder at forsøk de har utført viser at såkalt en spesiell protein-kilde reduser nivået av stoff som kan gi muddersmak på matfisk som er oppdrettet i RAS-systemer frem til slakt.
Denne artikkelen er tre år eller eldre.
Ifølge FishFarmingExpert har KnipBio gjort tester som konkluderer med at fôr som inneholder 5 % av et såkalt single cell protein (SCP) har betydelig lavere nivåer av geosmin og methylisoborneol (MIB), forbindelsene som er ansvarlige for å gi fisk produsert i RAS en smak som beskrives som jordaktig, muggen eller som muddersmak.
Det Massachusetts-baserte selskapet hevder deres encelleprotein er det første ernæringsbaserte alternativet for næringen som vil fjerne disse smaksstoffene fra fisken.
- Bismak kan være et alvorlig problem for RAS-anleggene som produserer matfisk. Standardløsningen er å gjennomføre en renseprosess hvor fisken overføres til tanker som inneholder rent vann og fôr fjernes. Prosessen kan vare så lenge som 14 dager, og i løpet av denne tiden mister fisken kroppsmasse, påpeker administrerende direktør i KnipBio, Larry Feinberg.
- Våre forsøk indikerer at behovet for rensing potensielt kan elimineres når fisk får tilført en diett som inneholder vårt SCP, noe som kan gi betydelig forbedret RAS-økonomi, bedre prosess-pålitelighet og økt forbrukertilfredshet, sier han.
KnipBios patenterte prosess bruker såkalte metylotrofe bakterier for å produsere encelleproteiner.
I juni 2019 kunngjorde de et gjennombrudd i sin forskning, der de fikk til å produsere SCP fra biprodukter av etanolfermentering.
- Slike biprodukt er billig, det er mye av det, og det er iboende bærekraftig med praktisk talt ingen miljøavtrykk, hevdes det.